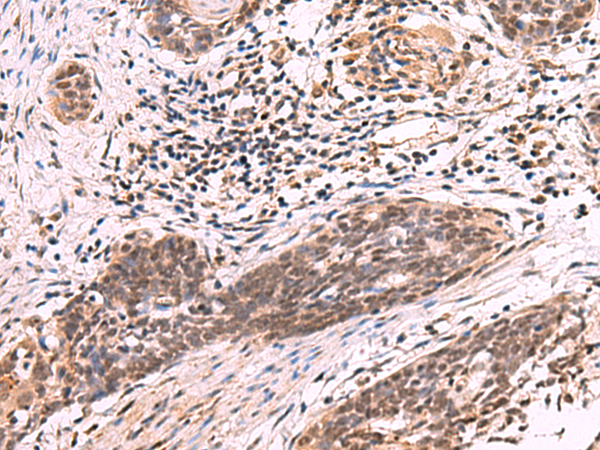

中文名稱: 兔抗ARIH2多克隆抗體
|
Background: |
The protein encoded by this gene is an E3 ubiquitin-protein ligase that polyubiquitinates some proteins, tagging them for degradation. The encoded protein upregulates p53 in some cancer cells and may inhibit myelopoiesis. Several transcript variants encoding different isoforms have been found for this gene, although the full-length nature of some of them have not been determined yet. |
|
Applications: |
ELISA, WB, IHC |
|
Name of antibody: |
ARIH2 |
|
Immunogen: |
Fusion protein of human ARIH2 |
|
Full name: |
ariadne RBR E3 ubiquitin protein ligase 2 |
|
Synonyms: |
ARI2; TRIAD1 |
|
SwissProt: |
O95376 |
|
ELISA Recommended dilution: |
5000-10000 |
|
IHC positive control: |
Human tonsil and Human esophagus cancer |
|
IHC Recommend dilution: |
50-300 |
|
WB Predicted band size: |
58 kDa |
|
WB Positive control: |
Human heart tissue lysate |
|
WB Recommended dilution: |
1000-5000 |

購物車
購物車 幫助
幫助
 021-54845833/15800441009
021-54845833/15800441009
